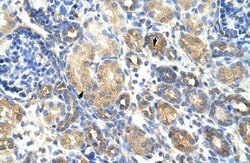
GNB1L Antibody, Novus Biologicals:Antibodies:Primary Antibodies

missing translation for 'onlineSavingsMsg'
Learn More
Learn More
GNB1L Antibody, Novus Biologicals™
Rabbit Polyclonal Antibody
£378.00
Specifications
| Antigen | GNB1L |
|---|---|
| Applications | Western Blot, Immunohistochemistry, Immunohistochemistry (Paraffin) |
| Classification | Polyclonal |
| Conjugate | Unconjugated |
| Form | Purified |
Description
GNB1L Polyclonal specifically detects GNB1L in Human samples. It is validated for Western Blot, Immunohistochemistry, Immunohistochemistry-Paraffin.Specifications
| GNB1L | |
| Polyclonal | |
| Purified | |
| RUO | |
| Q9BYB4 | |
| 54584 | |
| IgG | |
| Protein A purified |
| Western Blot, Immunohistochemistry, Immunohistochemistry (Paraffin) | |
| Unconjugated | |
| Rabbit | |
| Signal Transduction | |
| DGCRK3, G-protein beta subunit-like protein, guanine nucleotide binding protein (G protein), beta polypeptide 1-like, guanine nucleotide binding protein beta-subunit-like polypeptide, guanine nucleotide-binding protein subunit beta-like protein 1, GY2WD40 repeat-containing protein deleted in VCFS, KIAA1645, WD repeat-containing protein 14, WDR14G protein subunit beta-like protein 1, WDVCF | |
| GNB1L | |
| Primary | |
| This product is specific to Subunit or Isoform: beta-like protein 1. |
Spot an opportunity for improvement?Share a Content Correction
Product Content Correction
Your input is important to us. Please complete this form to provide feedback related to the content on this product.
Product Title